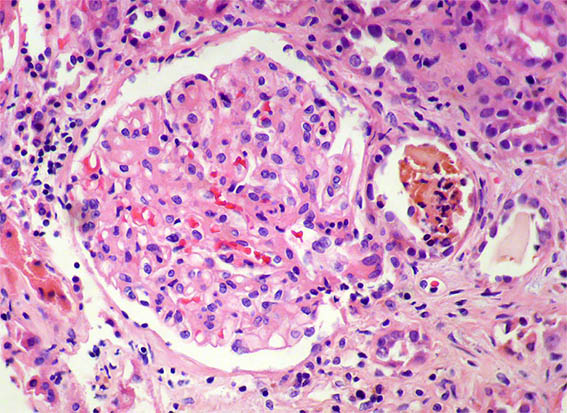
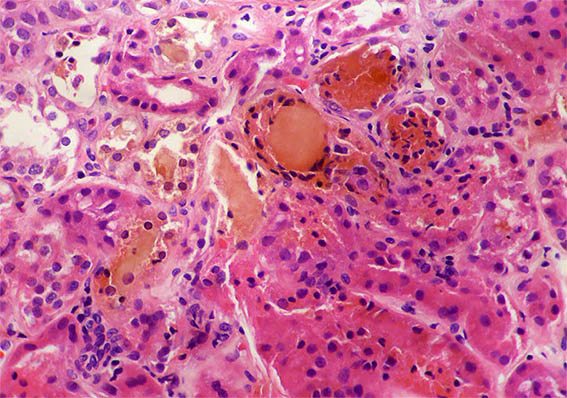
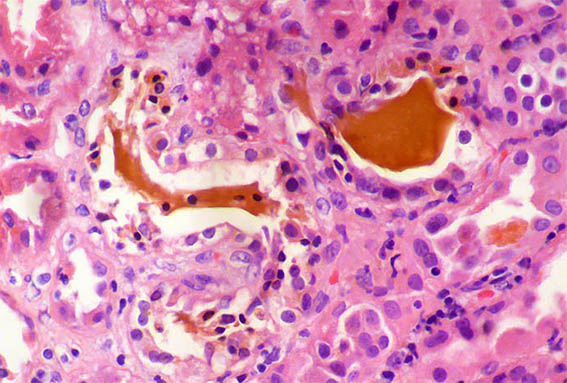

|
|
CASE
219 (May 2024)
Clinical information
A 40-year-old man presented with severe acute liver failure secondary to hepatitis A virus infection, and acute kidney injury.
More relevant laboratory tests: thrombocytopenia (76,000), hyperbilirubinemia (7.1 mg/dL), transaminitis (1.830 U/L and 2.320 U/L), and elevated INR. Serum creatinine: 5.2 mg/dL, BUN: 78 mg/dL, proteinuria: 100 mg/dL, without microhematuria.
A kidney biopsy was performed. Look at the images.

Figure 1. H&E, X100.

Figure 2. H&E, X200.

Figure 3.
H&E, X200.

Figure 4. H&E, X400.
Figure 5. H&E, X400.
Figure 6. H&E, X400.
Figure 7. H&E, X400.

Figure 8. H&E, X400.

Figure 9. PAS, X400.

Figure 10. Masson's trichrome stain, X200.

Figure 11. Methenamine-silver stain, X200.

Figure 12. Fontana-Masson stain, X200.
Direct immunofluorescence for IgA, IgG, IgM, C3, C1q, kappa and lambda: Negative. Iron stain: negative.
What is your diagnosis?
See
diagnosis and discussion
[Top]
|
|